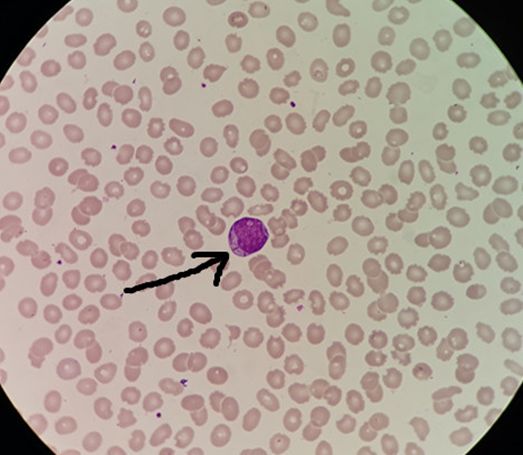

一例外周血细胞内发现Auer小体引发的感想

一门诊患者血常规,仪器无特别报警提示(不是现在主流仪器,所以提示信息有些少),散点图提示异常,血小板低达到复检规则,询问同事采血过程顺畅,涂片镜检,直接上图。女、26岁,无其他信息

图 第一次血常规结果

图 第一次外周血血片,细胞内含Auer小体(拍照技术还需加强)

图 第一次外周血血片

图 第一次外周血血片细胞内含Auer小体
心想不会又M3吧(因这段时间已发现两例,现在脑子都是它),又涂了几张片,未找到典型异常早幼粒细胞,也未找到柴捆细胞,赶紧询问患者病情,患者脸部眼角处有一块瘀斑已有一段时间不散,皮下有少量出血点、牙龈反复出血不止,这个症状,感觉不妥,白血病应该是跑不掉了,但是至于是不是M3这个不好说,毕竟血片提供给我们的信息有限,需马上进一步检查明确诊断。
因目前本院在骨穿这一块还不是很完善,与医生沟通后再和病人说明情况避免剧烈运动建议赶紧到上级医院做进一步检查。
以为这个事暂时告一段落。笔者有个习惯对于异常结果,在能去追踪的情况下都会去追踪,找上级医院老师了解最终诊断结果,因基层医院病例少,这样也是一种较好的学习方法。
患者走后,把患者名字及拍下的结果与图片发给上级医院老师帮忙分析,异常细胞无疑,至于是不是M3不好说,第二天下班时老师突然打来电话,询问是否有该患者的联系方式,因该患者去上级医院门诊做了血常规与细胞形态,值班人员可能由于标本量太多较忙的原因可能漏了,数值差不多,但细胞发了未见异常。
我们俩心里都咯噔一紧,M3的话拖延就很危险了,但当天我们都没有打电话通知患者,这也是现在感觉较愧疚的一件事,打算等患者第二天如不来复查就打电话询问患者是否去其他医院检查。
第二天在忙碌的工作中同事和我说那个病人又来了,心里感觉踏实了些,赶紧询问病人情况,症状有没有加重,有没有其他不适,看见病人脸上瘀斑依旧不散。病人说这两天吃了肉,来复查看看。
这解释,采完血之后马上推片、染色上图。

图 相隔一天的血常规结果,无很大差异
图 相隔一天的血片,细胞内含Auer小体

图 相隔一天的血片

图 相隔一天的血片,“屁股”样核细胞让人不安,较少但难找到其他类似,(让我想起了一首歌:终于等到你,还好没放弃)

图 相隔一天的血片,细胞内含Auer小体
这一次虽然血常规结果数值差不多,但是血片内的异常细胞与奥氏小体却比一天前的多了不少,这些也是一些仪器所发现不了的,涂了几张片也找不到典型柴捆细胞,但是M3的预感越来越强烈了,心想这次一定要让这个病人去做进一步检查。
马上打电话和上级医院老师联系说明情况,老师与那边医生联系好后,发结果备注好之后和患者沟通,告知患者必须去做进一步检查,到上级医院的哪个地方哪个科室找哪个医生,之后联系患者得知患者已做检查,等结果。
到了一天后的早上老师发来图片说找到了柴捆细胞了,之后骨穿、流式、染色体、融合基因结果,最后确诊M3!
过程有些曲折,但最终还是确诊了,作为一个医务工作者,一个检验人我们必须对我们的结果负责对病人负责。感谢上级单位老师的帮忙和认真的付出让这个病人能及时得到治疗!

图 相隔几天后老师在患者血片中找到的柴捆细胞
骨髓与流式结果:





染色体与融合基因结果:



奥氏(Auer)小体:是由异常的初级颗粒融合而成,呈红色棒状或针状物质,在细胞化学研究的基础上,其形成认为是白血病细胞浆内免疫球蛋白晶状体,也有人认为是由嗜苯胺兰颗粒融合而成的浆内包涵物[1];有资料报道,通过酶类、脂类、蛋白质、核酸类等18种化学染色证实, Auer小体除含有过氧化物酶和酸性磷酸酶外,也含有糖类和脂类成分[2]。
在骨髓或外周血涂片经瑞氏-姬姆萨染色后, 在光学显微镜下找到Auer小体基本可确诊为AML,所以 Auer小体是AML的形态学特异性诊断标志之一[3]。
近些年,各种先进的全自动血细胞分析仪被广泛应用,由于自动分析仪的普及,人们过度依赖自动化设备,传统的显微镜细胞形态分析技术逐渐被淡忘,在血细胞内部结构以及形态检测方面,血细胞分析仪还存在不足之处,有时标本量大任务较重时,检验人员未能及时进行血涂片复查镜检,随之而来的问题是导致异常细胞漏检的情况时常发生[4],所以我们检验人不能淡忘我们手中还有显微镜这个武器,显微镜是我们检验人的火眼金睛,要发挥它最大的作用。

终于尘埃落定,患者终于可以治疗,心里的石头落下了,但随之而来感到有些伤感,一个白血病又意味着一个家庭陷入困难,心里很不是滋味,我们能做的确实少之又少,能做的就是认真负责的对待每一份标本,每一份检查报告,及时发一份准确可靠的报告给临床做参考,及时对疾病进行确诊,让患者及时得到治疗。
科室应制定符合本科室的相关复检规则,患者在进行血常规检测结果触发复检规则时,应及时进行血涂片检查,复检规则执行起来一定会有不少收获。
血涂片检查可提高对异常细胞的筛选能力和诊断水平,能够为临床诊断提供更全面、直观的依据,对保证血常规检验质量、提高血常规检验准确性与符合率具有重要作用,可有效弥补血液分析仪检验的不足,减少误诊及漏诊的出现,以免患者错过最佳的治疗时间。
· 参考文献
[1]王风计.血液细胞学[M].天津:天津科技出版社, 1998:115.
[2]刘永春, 李彦会, 张秀玉, 等.A uer小体的细胞化学研究[J].白血病杂志, 1996, 5 (2) :108—109.
[3]李早荣,王晓君,寿爽,吴秋花,孙长贵.Auer小体及富含Auer小体的早幼粒细胞白血病[J].现代检验医学杂志,2006(06):66-67.
[4]战伟,刘新涛.血常规报告中异常细胞少检和漏检的探讨[J].大连大学学报,2017,38(03):59-62

